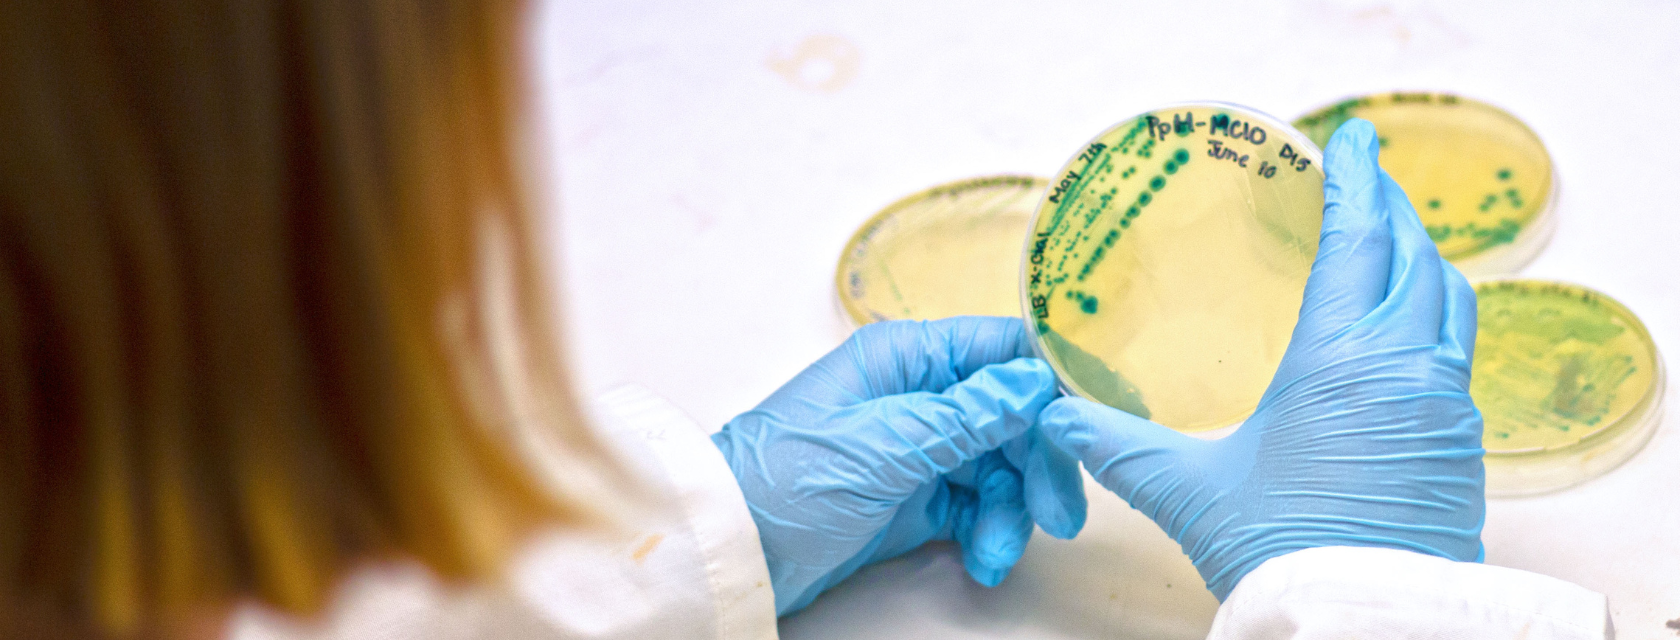
student looks at bacteria on petri dish

Microbiology and Immunology
Why Study Microbiology and Immunology at U of G?
From global pandemics to the diversity of our gut microbiome, microorganisms, including bacteria, viruses, and fungi, are everywhere and shape our health, environment and futures.
Microbiology and Immunology provides a foundation for understanding how microorganisms interact with our bodies and the environment to either promote health or evade immune systems and treatments, and how our immune systems recognize and protect us against pathogens and other threats.
You’ll learn from award-winning faculty leading groundbreaking research in the fields of gut microbiology, host-microbial interactions, antibiotic and antifungal resistance, vaccine development and evaluation, and biotechnology.
Note: The Microbiology and Immunology major was previously known as Microbiology. The new name is effective for the incoming fall 2026 class.
Gain a Breadth of Knowledge
After building a foundation in the biological sciences in first year, you’ll delve deeper with courses in microbial diversity, genetics, cellular biology, and biochemistry. In upper years, you can focus your studies by choosing from electives in a wide array of topics, including virology, viral immunology, medical virology, mycology, food microbiology, enzymology, and parasitology.
Practical Lab Skills
Microbiology and Immunology is a lab-intensive program, with practical training built into nearly every semester. Building from the basics, you’ll learn essential techniques ranging from PCR and western blotting to flow cytometry and tissue culture, along with bioinformatic and data analysis skills. Students are also invited to design and test their own research questions through fourth-year independent research projects.
Hands-on Work Experiences
Students in the co-op program gain valuable work experience while earning their degree. Previous co-op employers include pharmaceutical companies, hospitals, agri-food and supply companies, and government and academic labs.
To see all courses offered in the Microbiology and Immunology program, visit our Academic Calendar.
Events and Webinars Available Now

Future Gryphon Webinar Series
Canadian high school students are invited to connect with Admission Services through several virtual events this winter. Register today to learn more about campus, scholarships, tuition, housing and more!

International Virtual Open House
Prospective international students and their families are invited to explore our International Virtual Open House! Watch the recordings to learn more about programs, scholarships and life in Canada, plus hear current students and admission experts.
- Top Comprehensive University
- in Canada (Maclean’s)
- Top 150 in the World
- for Life Sciences (Times Higher Education 2026)
- Top 20% in the World
- for Biological Sciences (QS World University Rankings by Subject 2025)
- Top 4 in Canada
- for Microbiology (EduRank 2025)
Careers in Microbiology and Immunology
Microbiology and Immunology students learn a broad range of skills that are highly sought after by employers in both public and private sectors, including in the growing health and biotechnology sectors. Many graduates go on to pursue advanced studies in medicine, immunology, microbiology and bioinformatics.
Here are a few careers our graduates have successfully pursued:
- Medical professionals (physicians, dentists, specialists, gastroenterologists, nurses, clinicians, medical associates, etc.)
- R&D scientists and technician (medical, health, biotechnology and agricultural sectors)
- Research analysts and technicians (government and private sectors)
- Quality assurance
- Clinical labs
- Product development
- Production & product safety
- Entrepreneurs (medical, health, biotechnology and agricultural sectors)
- University professors
- Health researchers (government and private sectors)
- Biotechnology (pharmaceuticals, drug development, product development, food production and safety, etc.)
- Bioinformaticians
Gain Valuable Experience Through Co-op
The Microbiology and Immunology co-op is a five-year program that includes four paid work terms. Apply what you’ve learned in the classroom to the real world, with hands-on work experiences available in private, non-profit, and governmental organizations. Benefits of co-op include:
- Relevant work experience
- Up to 16 months of work experience
- Earning while learning
- Career exploration
- Professional networking
Students can apply for the co-op program directly from high school or later for in-course admission. Learn more about the Microbiology and Immunology co-op program.
Hear From Microbiology and Immunology Students and Graduates

During my co-op at Johnson & Johnson, I was trained in critical lab tests and completed a project using lab skills I learned at school that resulted in the use of a disinfectant still being used today. This experience confirmed my interest in working in industry, and I was thrilled to accept a role there post-graduation.

During my undergraduate studies in Microbiology and Immunology, I had the opportunity to complete my co-op work terms at a food manufacturing company for four semesters. The co-op program has helped me gain more insights into regulatory affairs, quality assurance, shelf-life studies, and how food safety impacts our daily lives! The program is designed with numerous courses that include extensive laboratory work, preparing me for literature review and scientific research. Today, I work at the Ministry of Agriculture, Food and Rural Affairs (OMAFRA), Government of Ontario as a Food Safety Advisor. I am grateful and proud to say I am a Gryphon!

I chose to study Microbiology and Immunology at Guelph for two key reasons. First, the university is renowned for fostering an inclusive and supportive community that promotes academic and personal growth. Second, the program's curriculum stands out for its strong emphasis on industrial and research applications, equipping students with practical skills and knowledge relevant to real-world challenges.

Through volunteer/work connections and research-based courses, the Microbiology and Immunology program offers countless opportunities to gain hands-on experience. I’ve learned and applied lab techniques during courses, like Advanced Methods in Microbiology. In this course, we collaborated with Tiny Earth to conduct research projects investigating antimicrobial-producing bacteria in Canadian soil, aiming to find novel antibiotics. At my job in a university research lab, I’m also constantly exposed to sophisticated laboratory techniques, like proteomics.

One thing that has stood out about the Microbiology and Immunology program has been how incredible the faculty and staff have been. I've seen how supportive and knowledgeable they are through classes and working closely with Dr. Allen-Vercoe and Dr. Cox during co-op placements. In these labs, I learned how the class content and laboratory techniques I had been learning could apply to research. This included researching antibiotic resistance in E. coli, using "Roboguts" to test the effect of a common food colourant on the human gut microbiome, and discovering new bacterial species in fecal samples from Yanomami individuals (a group of Indigenous people in the Amazon).

What excites me most about my fourth year is the fourth-year research project. You can conduct your own research and ask your own questions. So you get to take all the lab experience that you’ve had in the last couple of years of university, apply it, but then also really tap into your own interests and ask the questions that you want to know the answers to.
Discover More Options
Students considering Microbiology and Immunology may also be interested in Molecular Biology and Genetics, Biochemistry, Bio-Medical Science, or other majors.
Admission Requirements
Explore admission requirements for Canadian, international, transfer, and mature students. Start your journey today!
Scholarships & Bursaries
We offer a wide range of financial aid programs to assist with funding your education at the University of Guelph.
Tour Our Campus
Through virtual tours, presentations, webinars and in-person tours, get familiar with the University of Guelph campus.
Have Questions?
Learn more about how to connect, discover, and engage with programs, facilities and life at the University of Guelph.